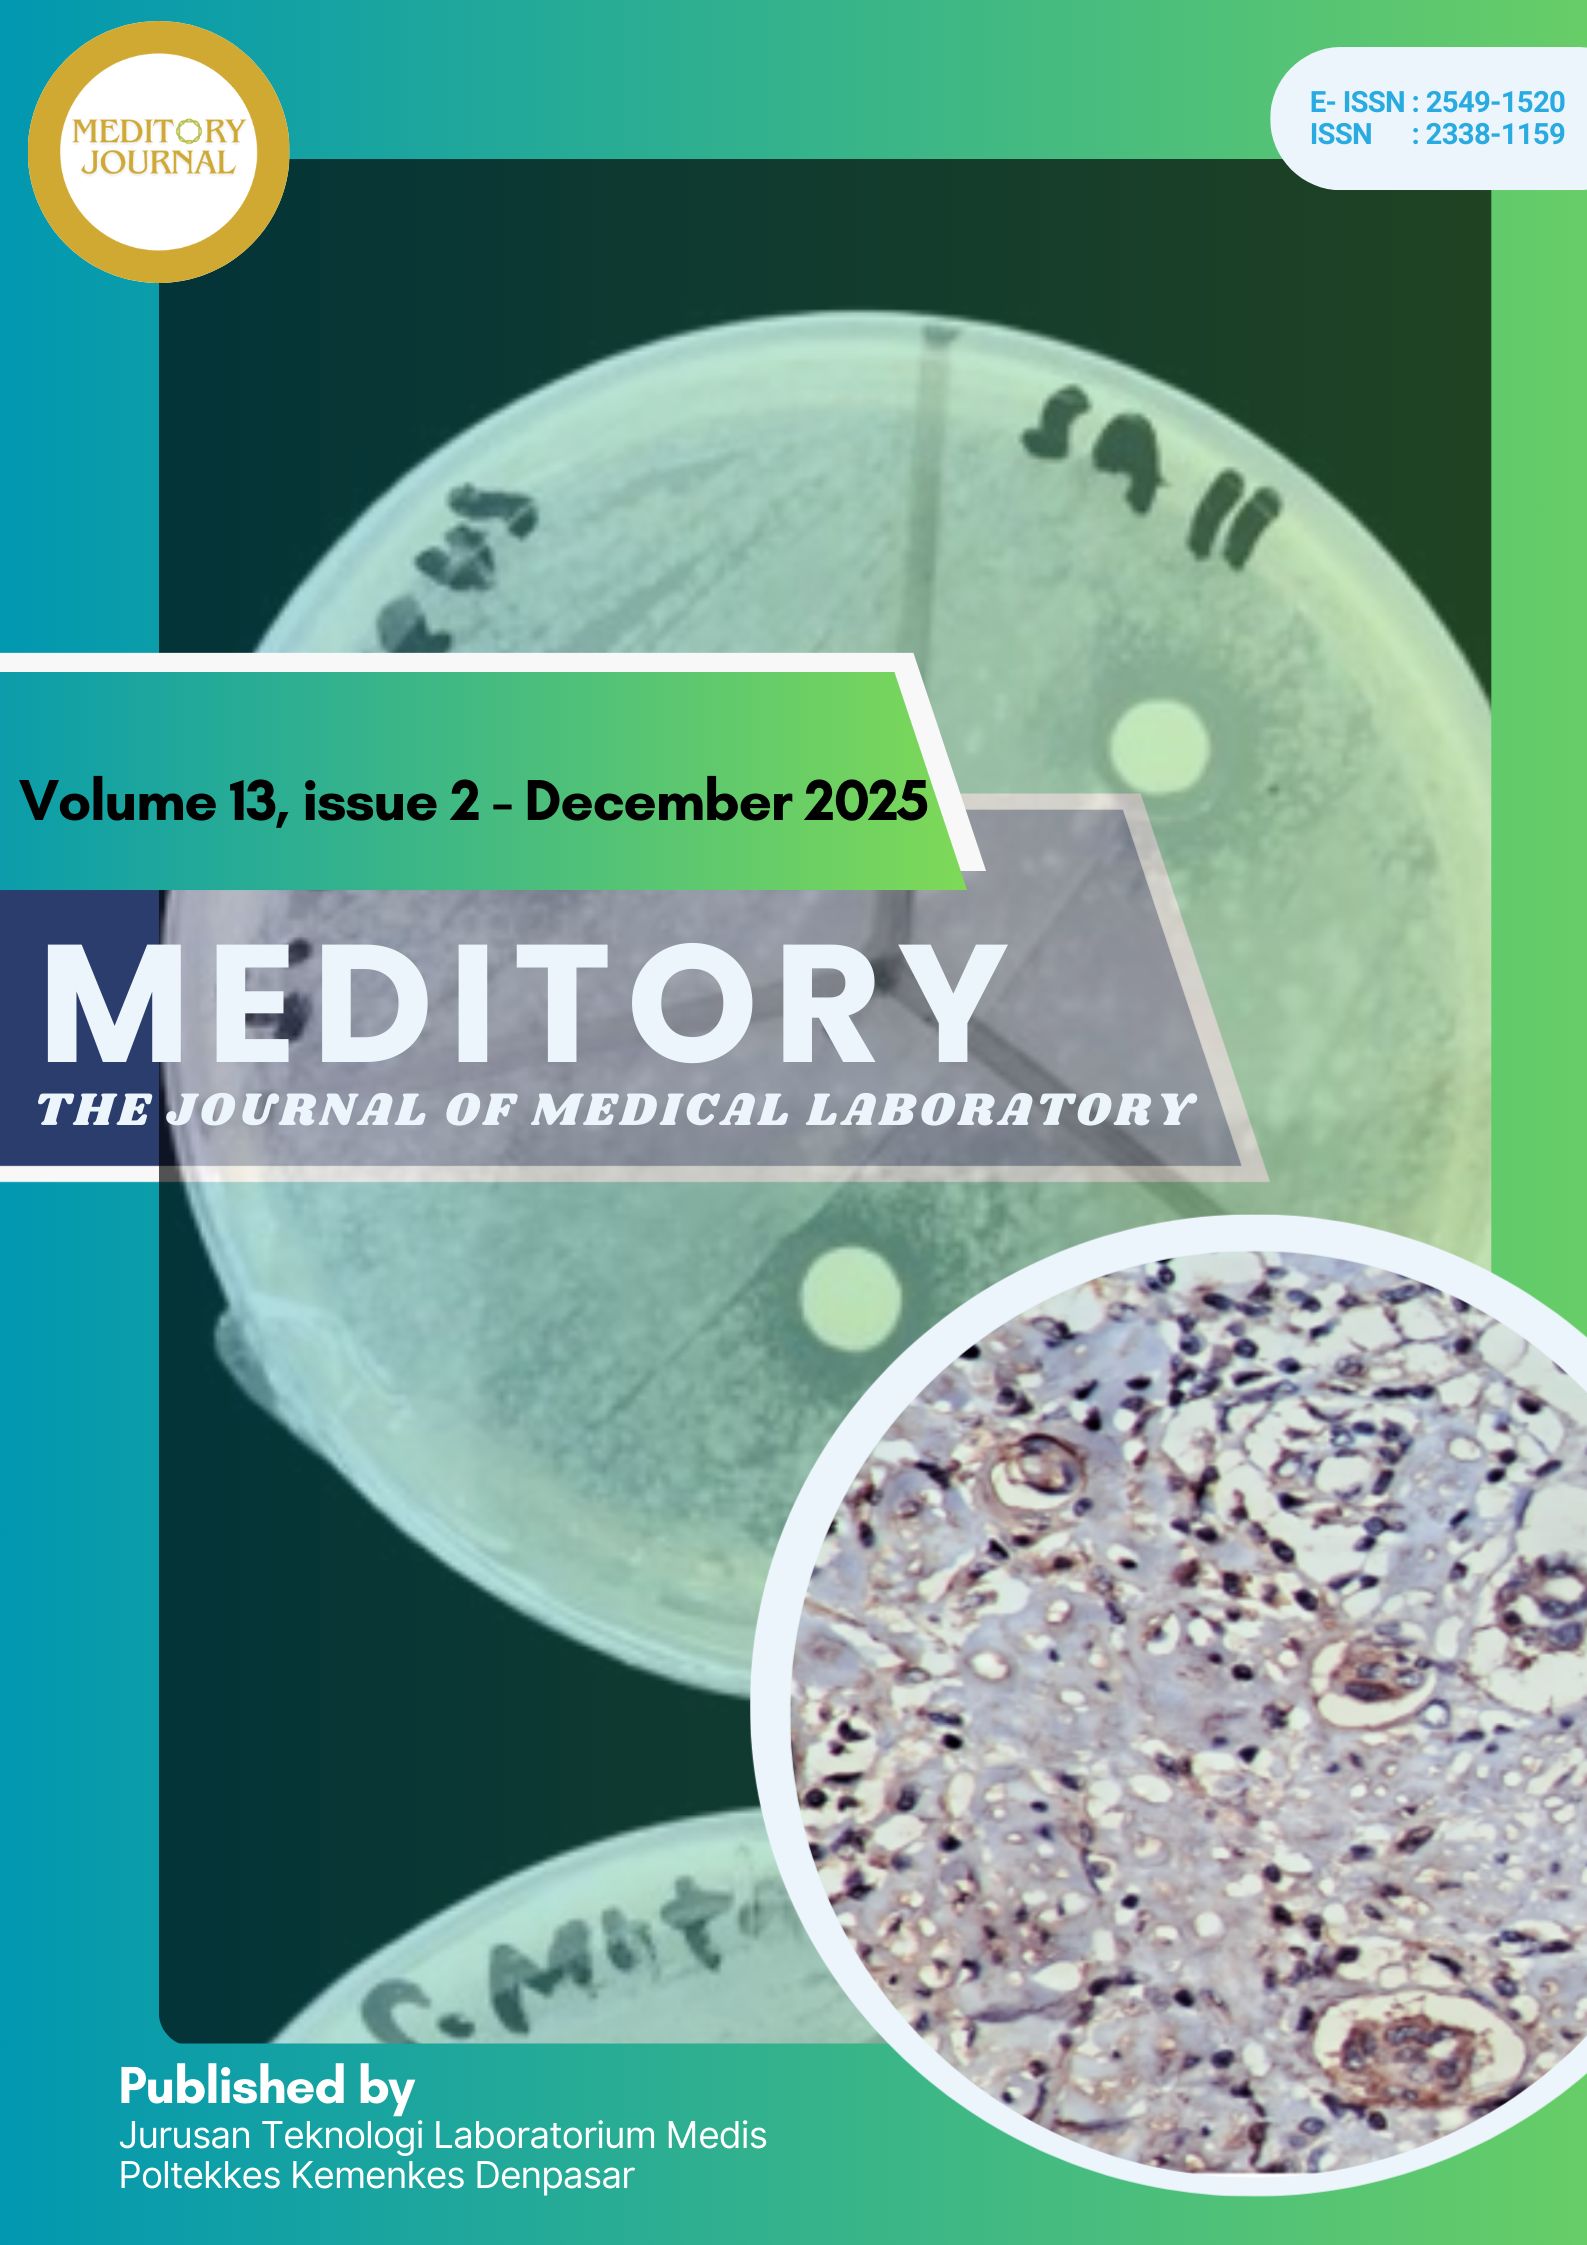
View Vol. 13 No. 2 (2025): Meditory, Volume 13 No. 2 Tahun 2025

Vol. 13 No. 2 (2025): Meditory, Volume 13 No. 2 Tahun 2025
Research Articles
-
DIAGNOSTIC VALIDITY ANALYSIS OF NS1-BASED RAPID TEST COMPARED WITH RT-PCR FOR DENGUE DETECTION IN BATAM
DOI : 10.33992/meditory.v13i2.4801 Abstract View : 217 STATEMENT OF MANUSCRIPT AUTHENTICITY downloads: 0 ethical approval downloads: 0 Data Set downloads: 0 turnitin score downloads: 0 turnitin score final downloads: 0 PDF downloads: 132 -
ASSOCIATION BETWEEN FASTING BLOOD GLUCOSE AND C-REACTIVE PROTEIN LEVELS IN TYPE 2 DIABETES MELLITUS PATIENTS
DOI : 10.33992/meditory.v13i2.4903 Abstract View : 106 STATEMENT OF MANUSCRIPT AUTHENTICITY downloads: 0 data set downloads: 0 PDF downloads: 79 -
HEMATOPOIETIC EFFECTS OF ETHANOLIC EXTRACT FROM Alternanthera sissoo ON ERYTHROCYTE, HEMOGLOBIN, AND HEMATOCRIT LEVELS IN ANEMIA-INDUCED FEMALE WISTAR RATS
DOI : 10.33992/meditory.v13i2.4714 Abstract View : 89 ethical approval downloads: 0 PDF downloads: 72 -
THE EFFECT OF FRANGIPANI FLOWER ETHANOL EXTRACT ON SUPEROXIDE DISMUTASE (SOD) LEVELS IN MALE RATS EXPOSED TO CIGARETTE SMOKE AND VAPE
DOI : 10.33992/meditory.v13i2.4826 Abstract View : 76 PDF downloads: 53 Etical clearance downloads: 0 ethical approval downloads: 0 raw data downloads: 0 statistic data downloads: 0 Dokumentasi penelitian downloads: 0 Dokumentasi penelitian 2 downloads: 0 Dokumentasi penelitian 3 downloads: 0 foto-foto penelitian downloads: 0 frangipani flower photo downloads: 0 final turnitin score downloads: 0 -
GAS CHROMATOGRAPHY-MASS SPECTROMETRY (GC-MS) PROFILING AND ANTIBACTERIAL ACTIVITY OF SECONDARY METABOLITES PRODUCED BY Bacillus sp. SA11 FROM MANGROVE SOIL
DOI : 10.33992/meditory.v13i2.4317 Abstract View : 135 PDF downloads: 69 Ethical Clearance downloads: 0 Supplementary Table downloads: 0 Figure 1 downloads: 0 Statement of manuscript authenticity downloads: 0 turnitin score downloads: 0 GC-MS chromatogram downloads: 0 NIST GC-MS Bacillus SA11 database result downloads: 0 WILEY database hits compounds associated with the ethyl acetate extract of Bacillus SA11. downloads: 0 -
GROWING Plasmodium berghei ANKA (PbA) FROM FROZEN AND FRESH DONORS: A COMPARATIVE STUDY
DOI : 10.33992/meditory.v13i2.4315 Abstract View : 74 PDF downloads: 60 ethical approval downloads: 0 STATEMENT OF MANUSCRIPT AUTHENTICITY downloads: 0 Data Set downloads: 0 turnitin score downloads: 0 final turnitin score downloads: 0 -
HIGH MATRIX METALLOPROTEINASE 9 EXPRESSION AS A RISK FACTOR OF LYMPHOVASCULAR INVASION IN CERVICAL CARCINOMA
DOI : 10.33992/meditory.v13i2.4204 Abstract View : 52 PDF downloads: 46 Matrix Metalloproteinase 9 Expression as a risk factor of Lymphovascular Invasion in Cervical Carcinoma downloads: 0 article downloads: 0 manuscript of authenticity downloads: 0 Data for reaserch downloads: 0 data excel sample downloads: 0 turnitin score downloads: 0 -
FORMULATION OF MORINGA AND EGGSHELL-BASED MOUTHWASH AS ANTIBACTERIAL AGAINST Streptococcus mutans
DOI : 10.33992/meditory.v13i2.4114 Abstract View : 87 PDF downloads: 92 Untitled downloads: 0 Formulation of Moringa and Eggshell-Based Mouthwash as Antibacterial Against Streptococcus mutans downloads: 0 Formulation of Moringa and Eggshell-Based Mouthwash as Antibacterial Against Streptococcus mutans downloads: 0 Formulation of Moringa and Eggshell-Based Mouthwash as Antibacterial Against Streptococcus mutans downloads: 0 turnitin score downloads: 0 turnitin score final downloads: 0 -
THE EFFECT OF CHEMOTHERAPY ON BLOOD CELL COUNTS IN POST-MASTECTOMY BREAST CANCER PATIENTS
DOI : 10.33992/meditory.v13i2.4096 Abstract View : 80 THE EFFECT OF CHEMOTHERAPY ON BLOOD CELL COUNTS IN POST-MASTECTOMY BREAST CANCER PATIENTS downloads: 0 THE EFFECT OF CHEMOTHERAPY ON BLOOD CELL COUNTS IN POST-MASTECTOMY BREAST CANCER PATIENTS downloads: 0 Statement of Manuscript Authenticity downloads: 0 ethical approval downloads: 0 turnitin score downloads: 0 turnitin score final downloads: 0 PDF downloads: 55 -
MEAN PLATELET VOLUME AND DISTRIBUTION WIDTH IN TYPE II DIABETES
DOI : 10.33992/meditory.v13i2.4278 Abstract View : 69 PDF downloads: 54 Supplementary data downloads: 0 Ethical Clereance downloads: 0 Research data downloads: 0 Statement of manuscript authenticity downloads: 0 final turnitin score downloads: 0
Review Articles
-
PSEUDOURIDINE AND N1-METHYLPSEUDOURIDINE IN mRNA VACCINES MODULATE RETINOIC ACID INDUCIBLE GENE I (RIG-I) AND TOLL-LIKE RECEPTORS (TLR) ACTIVATION
DOI : 10.33992/meditory.v13i2.4781 Abstract View : 109 PDF downloads: 82 STATEMENT OF MANUSCRIPT AUTHENTICITY downloads: 0 turnitin score downloads: 0